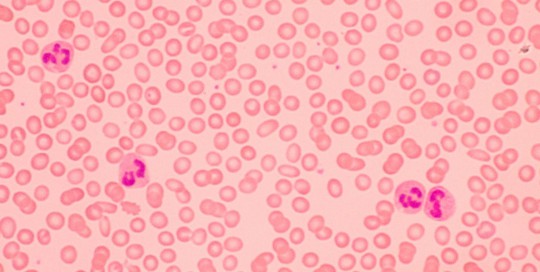

Le laboratoire Génélab offre un service d’analyse toxicologique afin de rechercher la présence de drogues, de médicaments, de poisons, d’alcools ou d’autres substances dans le corps d’une personne. Ce service peut être utile en cas d’ingestion d’un poison, tout comme dans certaines industries pour le suivi du personnel d’une entreprise.
Bactériologie
root2023-10-14T10:55:50+00:00Le laboratoire Génélab se charge du diagnostic des infections bactériennes dans les selles, les urines, les crachats etc, grâce à l'isolement et l'identification des bactéries, puis réalise un antibiogramme sur les bactéries isolées pour permettre à votre médecin d’adapter votre traitement. AUTRE SPÉCIALITÉS
Immunologie
root2023-10-14T10:53:52+00:00Le laboratoire Génélab dispose d’une plateforme d’immunologie, pour le diagnostic et du suivi des patients souffrant de maladies immunologiques, telles que les maladies auto-immunes, les maladies inflammatoires, les maladies allergiques, les maladies infectieuses et les déficiences immunitaires. AUTRE SPÉCIALITÉS
Spermiologie
root2023-10-14T10:06:59+00:00Nous analysons la qualité et la quantité des spermatozoïdes, pour vous apporter des réponses aux problèmes d’infertilité de votre couple. En cas d’anomalies sur vos spermatozoïdes, votre médecin traitant peut vous proposer un traitement le mieux adapté. AUTRE SPÉCIALITÉS
Parasitologie
root2023-10-14T10:52:12+00:00La plateforme de parasitologie du laboratoire Génélab effectue le diagnostic des maladies parasitaires telles que la recherche des vers intestinaux, le diagnostic de la toxoplasmose chez la femme enceinte et bien d’autres… AUTRE SPÉCIALITÉS
Biochimie
root2023-10-14T09:42:33+00:00Le laboratoire Génélab dispose d’une plateforme de biochimie qui rassemble toutes les analyses permettant d’évaluer le bon fonctionnement de plusieurs organes et fonctions, importants pour la santé, tels que le diabète, la fonction rénale, le foie, les maladies cardiovasculaires. Les analyses biochimiques peuvent être réalisées à jeun ou non.
Mycologie
root2020-02-08T08:46:00+00:00La mycologie est une branche de la médecine (humaine ou vétérinaire), plus spécifiquement de la Biologie médicale, qui consiste à isoler et caractériser les levures, les champignons filamenteux (ou champignons dimorphiques) dans divers liquides ou tissus d’origine humaine dans le but de caractériser l’origine mycologique ou non d’une pathologie. Principaux
Virologie
root2023-10-14T09:48:42+00:00La plateforme de virologie du laboratoire Génélab réalise les tests de routine pour le diagnostic et le suivi des infections virales humaines. Ce diagnostic virologique s’effectue par des méthodes indirectes à partir des tests rapides de diagnostics sérologiques. AUTRE SPÉCIALITÉS
Hématologie
root2023-10-14T09:39:26+00:00La plateforme d’hématologie du laboratoire Génélab permet de diagnostiquer les maladies liées aux trois familles des cellules sanguines (les globules rouges ou érythrocytes, les globules blancs ou leucocytes, les plaquettes). Parmi ces anomalies, on trouve l’anémie (déficit en globules rouges), les infections (augmentation des globules blancs) et les autres maladies du
Immuno-Hématologie
root2023-10-14T09:37:35+00:00La plateforme d’immunohématologie du laboratoire Génélab permet d’évaluer les propriétés antigéniques du sang, les réactions immunologiques correspondantes, et les pathologies qui y sont associées, tels que, les pathologies liées aux groupes sanguins, certaines pathologies auto-immunes, les incompatibilités fœto-maternelles, les réactions immuno-allergiques… AUTRE SPÉCIALITÉS